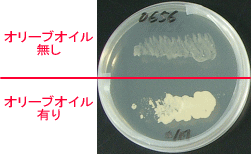
Malassezia furfurの培養条件比較

◆◇◆ ━━━━━━━━━━━━━━━━━━━━━━━━━━━ ◆◇◆
NBRCニュース No. 20(2013.4.1)
◆◇◆ ━━━━━━━━━━━━━━━━━━━━━━━━━━━ ◆◇◆
NBRCニュース第20号をお届けします。今号から新連載「特許微生物寄託のイ
ロハ」を開始しました。微生物の培養法では、お問い合わせの多いMalassezia
酵母を取り上げました。最後までお読みいただければ幸いです。
(等幅フォントでご覧ください)
======================================================================
内容
======================================================================
1.新たにご利用可能となった微生物株(2013年1月22日~3月19日)
2.微生物の培養法(10)
Malassezia(マラセチア、マラセジア)酵母の培養法
3.アジアの微生物 (8)
ミャンマー、 変わりゆく国
4.特許微生物寄託のイロハ (1)
特許寄託制度とは
5.微生物あれこれ(17)
オランダCBSに行ってきました
======================================================================
1.新たにご利用可能となった微生物株(2013年1月22日~3月19日)
======================================================================
酵母 5株、糸状菌 4株、細菌 13株、アーキア 2株、微生物ゲノムDNA 5種
類を新たに公開しました。
【新規公開株一覧】
https://www.nite.go.jp/nbrc/cultures/nbrc/new_strain/new_dna.html
======================================================================
2.微生物の培養法(10)
Malassezia(マラセチア、マラセジア)酵母の培養法 (山崎敦史)
======================================================================
Malassezia酵母は、クロボキン綱(Ustilaginomycetes)に属する担子菌系
の不完全酵母です。ヒトや動物を宿主とする皮膚常在菌で、これまでに報告さ
れている13種のうちMalassezia pachydermatisを除くすべての種が脂質要求性
を示します。
Malassezia furfur の培養条件比較(YM寒天培地、培養3日後) 上側:菌液のみ。下側:菌液とオリーブオイル この酵母の培養には、いくつかの培地が考案されており、Dixon's agar (Dixon agar、DA)やその改変培地 modified Dixon's agar(mDixon agar、 mDA)、Leeming and Notman Agar(LNA)やこれに改良を加えた培地として modified Leeming and Notman Agar(MLNA)等が使われております。特にMLNA 培地は、これまで報告されている全てのMalasseziaを培養することができると されています。また、YM寒天培地やサブロー寒天培地(Sabouraud agar)にオ リーブオイルを重層して培養することもできます。市販培地では、クロモアガ ーマラセチア/カンジダ(関東化学)で良好な生育が認められ、この培地には Malassezia各種の検出用のために、コロニーが発色する成分が含まれておりま す。NBRCではオリーブオイルを添加するMLNA 培地(NBRC No.1004培地)や、 NBRC No.103培地をMalasseziaの培養に用いております。これらの培地がうま く固まらないというご質問をいただいておりますので、今回はその培地の作製 法について紹介させていただきます。ポイントは、寒天培地が固化した後にオ リーブオイルを添加することです。全ての培地成分を混ぜてオートクレーブし ても、オリーブオイルが培地の水分と分離してしまい、上手く固化させること ができません。
![]() MLNA斜面培地 左:オリーブオイル添加前、 右:添加後 |
◆ 培地作製手順 (1) オリーブオイル以外の培地成分を混ぜ合わせま す。 (2) 加熱して寒天を溶かし、試験管に培地を分注し ます。 (3) 培地をオートクレーブ滅菌(121℃、15分)し ます。 (4) 培地に斜面ができるように試験管を傾け、常温 で1~2時間程度放置し、培地を固化させます。 (5) オリーブオイルを遮光瓶に入れてオートクレー ブし、60℃のインキュベーターに入れて、1時間 程度置き、水分を蒸発させておきます。 (6) 培地を使用する直前に、(5)で用意したオリーブ オイルを、固化した培地表面をおおう程度加え ます(例えば8 mlの培地で作製した斜面培地で は150µl 程度です)。オリーブオイルは培地に のせるだけです。 平板培地を作製する場合は(2)の操作は不要で、 (4)の操作の代わりにプレートに培地を注ぎます。 培養するときは、作製した寒天培地上に菌液を加 え、ループ等を使って寒天培地上でオリーブオイル と菌液を混ぜ合わせます。特に培養初期では、培地 が乾燥すると生育しない場合があります。培地の下 部に水分が残っていないような状態の時は、YM液体 培地を固形培地上に少量加えておくと、培養がうま くいきます。 |
【以下、2015年11月追記】
Malassezia restricta NBRC 103918およびMalassezia globosa NBRC 101597の培養に
おいて、LNA培地の方が良好な生育を示すことが分かりました。MLNA培地でも上記2株
は生育しますが、LNA培地はオリーブオイルを使用しないため、培地がべと付かず、
コロニーの観察や取扱いが容易になります。組成と作成方法は、オンラインカタログ
の菌株情報の培地(Medium)に記されている番号をクリックすると表示されます。
この組成等は The Yeast 第5版 で紹介されている内容に従っています。
======================================================================
3.アジアの微生物 (8)
ミャンマー、 変わりゆく国 (鶴海泰久)
======================================================================
ヤンゴンで飛行機を降りると、そこには改装された国際空港がありました。
市内は主要道路が整備され、走る車はほとんどが日本からの輸入車です。ミャ
ンマーは、海外諸国と距離を置いた時期を終え、経済発展に向けて急速に社会
構造を変えつつあります。
ミャンマーの多くの男性はロンジンという巻きスカートのような伝統的衣服
を着用し、女性はタナカという木の粉を頬に塗る化粧をしています。一方で街
にはソフトモヒカンやジャニーズヘアの青年が、髪を茶や金色に染めた艶やか
な衣服の女性と腕組み歩く姿がよく見られます。都市の建物はコンクリートや
煉瓦積みのマンションですが、少し郊外の農村地帯へ出るとタケやヤシで作ら
れた高床式の極めて簡素な住居が一般的です。日本の最新高級車が走る反面、
都市間連絡バスやトラックの荷台に椅子と幌を取り付けた民間バスが交通網の
主役を担っています。伝統と近代化が混在する過渡期の状態がこの国にはあり
ます。
3月17日、私たちは共同研究事業を再開するためミャンマーを訪れました。
NBRCは2004年にパセイン大学と共同研究を始めましたが、翌年、国内事情によ
って中断を余儀なくされました。その後の8年間は連絡すらままならない状態
が続きましたが、昨春から再開に向けた事務レベルでの調整を進め、今回の契
約に至りました。締結式ではバ・シュエー教育省副大臣の立会いの下、教育省
教育局と包括的覚書(MOU)を、パセイン大学と共同事業契約(PA)を結びま
した。副大臣は両国の長い友好関係の歴史に触れられ、ミャンマーの微生物資
源の活用と商業化が両国の科学技術と経済の発展につながることを期待すると
述べられました。
ミャンマーの国土はインド洋の海岸線から標高6,000 m級の山岳地まで広大
に拡がり、年間降水量が5,000 mm以上のモンスーン気候から1,000 mm未満のサ
バナ気候まで環境も多様です。そのため、未開拓の自然には人類が未だ利用し
ていない多種多様な生物資源が眠っていると考えられます。また、東南アジア
諸国で次第に失われつつある伝統的な食文化、例えばミャンマー独自の後発酵
茶Lepet-so(ラペ・ソー)などが今も受け継がれています。民族によっては鱠
(なます)やなれ鮨が食され、異なる魚醤や塩辛が調味料として使われている
そうです。
様々なメディアで報道されている通り、ミャンマーの発展の勢いはめざまし
く、中国・韓国や欧米を始めとした世界中の企業の注目を集めています。しか
しそのことが、それまで守られてきた生態系や生活・文化を一気に変える可能
性もあります。朝食にモヒンガ(つぶした豆と魚のスープをかけた米の麺)を
食べながら、できるだけ早くミャンマー固有の微生物を保全して、利用し続け
られる体制を整えたいと思いました。

左:MOU調印式、右:朝食にモヒンガ
======================================================================
4.特許微生物寄託のイロハ (1)
特許寄託制度とは (大野さやか)
======================================================================
NBRCを微生物を提供している機関としてご存じの方は多く、さらに、論文を
書く等の理由で微生物を寄託されている方もいらっしゃると思います。NBRCで
は、それ以外にも特許出願等のためだけに微生物をお預かりする事業も実施し
ています。その事業を実施している部署が、特許微生物寄託センター(NPMD)
と特許生物寄託センター(IPOD)です。IPODは、もともとは独立行政法人産業
技術総合研究所の機関でしたが、平成24年4月からNBRCで運営することとなり
ました。詳細は、次号以降にてお知らせいたします。
特許出願のために微生物を寄託するのは、出願者以外でもその特許を再現で
きなければいけない、という特許の原則のためです。微生物の働きにはブラッ
クボックスの部分が多く、さらに、特定の微生物のみがもつ性質を利用してい
ることが多いため、まさにその微生物を使用しないと特許の内容を再現できな
い場合があります。そのため、特定の機関に預け、必要な場合には入手できる
状況をつくる必要があるのです。ただし、NBRC株のように誰でも入手可能な微
生物である場合や遺伝子配列を記載することで酵素等が十分に再現可能となる
場合には、微生物を寄託する必要はありません。ちなみに、特許微生物寄託で
は、微生物の定義が一般的な「微生物」とは異なっており、動物細胞や種子な
ども含まれています。最初は本当に細菌などの微生物だけだったのですが、運
用している間にだんだん範囲が広がってしまったようです。
寄託の種類には2種類あり、日本の特許法に基づく国内寄託とブダペスト条
約に基づく国際寄託があります。国内寄託をした微生物は日本での特許のみ有
効なので、同じ微生物を利用して、ブダペスト条約の締約国に出願する場合に
は、国際寄託をするか、国内寄託から国際寄託へ切り替え(移管)しなくては
いけません。最近では、国内出願と同一の内容で加盟国へ一斉出願できる特許
協力協定(PCT)を利用する方も多くいらっしゃいますが、この場合にも、国
際出願日前に国際寄託への移管が必要です。PCT出願の場合は時間の制約があ
りますので、あらかじめ国際寄託にするか、早めに国際寄託へ移管することを
おすすめいたします。日本国内のみの特許出願をする場合でも、国際寄託した
微生物を利用しても問題はありません。ブダペスト条約は、それまで出願する
国それぞれに寄託をしなければいけなかった微生物を、条約に基づく国際寄託
当局(IDA)のいずれかに寄託していればすべての締約国において寄託したと
みなす条約です。この条約のおかげで、多くの方が出願するアメリカ、中国な
どへは、別途その国へ寄託をしなくてもよくなりましたが、一部の国について
は、締約国ではないため、仮に国際寄託をしていても別途その国に寄託をしな
くてはいけない場合があります。締約国かどうかは世界知的所有権機構(WIPO)
のホームページに締約国のリストがありますので、寄託や出願前に確認してく
ださい。

国際寄託制度の概要 特許微生物寄託された微生物は、特定の条件を満たした方にのみに分譲され ます。国内寄託された微生物を入手するには特許庁の証明を持っていることが 必要で、その証明書の取得には、(1) 特許権の設定登録があったとき、(2) 警 告を受けたとき、(3) 意見書を作成するために必要なときの3つの条件のいず れかを満たしている必要があります。国際寄託の場合、出願国によって入手の 条件が異なりますが、概ね日本の場合と同等です。 次回は、NPMDとIPODの違いとNBRCで一元的に運営することになった経緯につ いてご案内いたします。 【WIPO】 http://www.wipo.int/treaties/en/registration/budapest/ ====================================================================== 5.微生物あれこれ(17) オランダCBSに行ってきました (石田孝英) ====================================================================== オランダにあるCBS(Centraalbureau voor Schimmelcultures)という菌類 の研究所をご存じですか。100年以上の歴史がある世界最大の菌類のカルチャ ーコレクションですので、これまでに寄託したり分譲を受けたりした方もいる かもしれません。私は、このCBSで2月に行われたFungal Biodiversityという 2週間の講習会に参加してきました。今回の微生物あれこれではその時の様子 をお知らせしたいと思います。 この講習会は菌類の主要な分類群を座学と観察で学ぶもので、90分程度の講 義と2時間程度の顕微鏡観察を毎日午前と午後に10日間にわたって繰り返し行 いました。30近くの講義が10人以上の講師によって行われ、顕微鏡観察用に準 備された培養物も130種類以上に及びました。講義は分類学が中心であり、最 新の分子系統が反映された現代的なものでした。いずれの講義も投影資料が充 実し、話も上手で退屈することはありませんでした。また、細菌で開発された MALDI TOF-MSを用いた種の同定法の菌類への応用、種同定のための次世代DNA バーコード領域、ヨーロッパの植物防疫事情など、今後の菌学に重要と思われ る多くのことを学ぶことができました。参加者は、病院の検査技師、種子・花 卉会社の技術者、大学教官、学生など学歴も職種も多岐にわたりましたが、皆 さん講習会に満足した様子でした。日本人参加者は少ないとのことでしたが、 誰でも参加できる有意義な講習会ですので、興味のある方は次の機会に検討さ れてはいかがでしょうか。 講習会の合間にCBSの施設を見学し、職員と話をする機会もありました。CBS はカルチャーコレクション以外に6つの研究部門からなります。これらの研究 部門では、昔ながらの地道な研究で分類学に貢献する一方、世界中の研究者と 協力しながらビッグデータを扱うような研究も行っています。このような幅広 い研究活動によって、多くの研究者や菌株がCBSに集まり、その結果カルチャ ーコレクションの重要性も高まる、という好循環にあるように思われました。 全体的な感想として、CBSはカルチャーコレクションの巨人でした。10歳の NBRCでは100歳を超えるCBSにかなわない点もありますが、その一方で、標品の 作製方法や顧客対応など、NBRCの方が優れていると思われる点がいくつもあっ たことも事実です。NBRCでは、優れたところを伸ばし、CBSから学んだことを 生かしながら、ユーザーの皆様の期待に添えますよう、日々努力して参ります ので、今後ともよろしくお願いいたします。

CBS外観 ====================================================================== 編集後記 ====================================================================== 春、あたりを見回せば花が咲き誇る季節になりました。NBRCの周辺では、ウ グイスの声も華を添えています。春は卒業式や入学式等、出会いと別れの季節 でもあります。私もこの春に異動となり、NBRCニュース編集局を卒業します。 NBRCニュースをご愛読いただいている皆さま、大変お世話になりました。寂し さを感じますが、新しい出会いもあると言い聞かせております。今年度も皆さ まにとってすばらしい出会いがありますように。(JS) ◆◇◆ ━━━━━━━━━━━━━━━━━━━━━━━━━━━ ◆◇◆ ・NBRCニュースは配信登録いただいたメールアドレスにお送りしております。 万が一間違えて配信されておりましたら、お手数ですが、下記のアドレスに ご連絡ください。 ・ご質問、転載のご要望など、NBRCニュースについてのお問い合わせは、下記 のアドレスにご連絡ください。 ・掲載内容は予告なく変更することがございます。掲載内容を許可なく複製・ 転載されることを禁止します。 ・偶数月の1日(休日の場合はその前後)に配信しております。第21号は6月 3日に配信予定です。 編集・発行 独立行政法人製品評価技術基盤機構(NITE)バイオテクノロジーセンター NBRCニュース編集局(nbrcnews@nite.go.jp) ◆◇◆ ━━━━━━━━━━━━━━━━━━━━━━━━━━━ ◆◇◆









